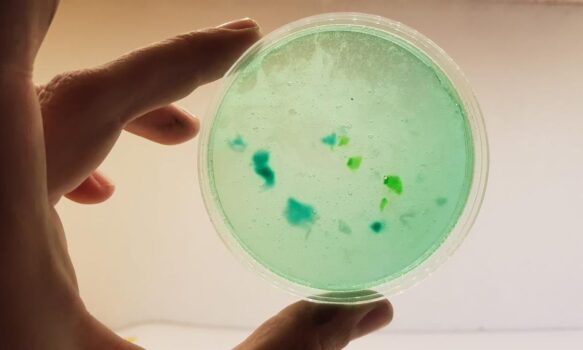

El Gobierno del Chubut, a través de la Secretaría de Ambiente y la Subsecretaría de Cultura, llevará a cabo las Primeras Jornadas de Ecomateriales, con la finalidad de interiorizar a los participantes en el rescate y reutilización de la “basura domiciliaria” para reducir desechos cotidianos y transformarlos en telas plásticas o biodegradables, que pueden servir como materia prima en la elaboración de otros objetos como billeteras, bolsos y artículos decorativos.
Los encuentros destinados a diseñadores, manualeros y público en general se desarrollarán de manera gratuita entre el 28 y el 30 de noviembre en el Salón Auditorio del Centro Cultural Provincial (CCP) de Rawson, y se trata de una actividad impulsada de forma conjunta con el municipio capitalino y el Consorcio GIRSU (Gestión Integral de Residuos Sólidos Urbanos).
Cronograma
El jueves 28 de noviembre se iniciarán las actividades con una visita a la Planta de Separación y Transferencia del GIRSU, ubicada sobre la Ruta Nacional N°3 entre Trelew y Puerto Madryn, donde los asistentes podrán conocer de primera mano el destino final de los desechos urbanos del Valle Inferior del Río Chubut (VIRCh).
Mientras que el viernes 29, el diseñador industrial de Trelew, Silvio Tinello, dará inicio al Taller de Experimentación con diferentes materiales sostenibles para transformarlos en bioplásticos, utilizando como materia prima descartes orgánicos como borra de café, hebras de té, cascara de huevo y de frutas, entre otros.
Por último, en la jornada del día sábado 30 de noviembre, se trabajará por la mañana con la diseñadora textil, Luciana Varela, del emprendimiento “Bolsa Red” de Puerto Madryn, con quien se llevará a cabo la experimentación y transformación de distintos tipos de plástico, convirtiéndolos en una tela que permite nuevos usos.
Por la tarde, se finalizará con la elaboración de muestras de diferentes bioplásticos.
Inscripciones
Estas Primeras Jornadas de Ecomateriales son gratuitas y tienen cupo limitado. Las inscripciones y consultas se realizan a través del correo electrónico meinteresacultura@gmail.com, y requiere de la recolección previa de los materiales ya que se trabajará con residuos que habitualmente se descartan en los hogares.
Del residuo al recurso
La contaminación por desechos plásticos es un problema significativo que impacta en el ambiente, es por eso que las acciones individuales trabajadas colectivamente impactan directamente en la reducción de desechos, potenciando su reutilización.
Los plásticos tardan cientos de años en descomponerse, deteriorando la calidad de los suelos, contaminando las aguas, produciendo lastimaduras y asfixias en la fauna marina, y causando también trastornos en la salud humana.
Como consumidores no podemos evitar el uso de plásticos, pero sí podemos generar grandes cambios colectivos con pequeñas acciones individuales como clasificar los residuos cotidianos, reutilizar envases, o transformarlos en materia prima para generar otros artículos de uso cotidiano como macetas, envoltorios, billeteras, bolsos, etc.
Estas Primeras Jornadas de Ecomateriales proponen no sólo generar conciencia ambiental sino también concretar la transformación de los residuos cotidianos que se producen en cada hogar, en un material sustentable, que se puede utilizar con fines creativos, en el diseño de objetos dándole a los materiales un nuevo uso.
Puertas Abiertas
El programa GIRSU “Puertas Abiertas” tiene como fin conocer el proceso de tratamiento de los residuos sólidos urbanos (RSU). De esta forma se puede ver cómo los residuos que se generan en el hogar llegan a las plantas de separación y transferencia, y cómo son tratados y separados para que luego los mismos puedan ser reutilizados e insertos nuevamente en el mercado.
Por medio del trabajo realizado en las plantas, los RSU son valorizados o tratados para disminuir los daños ambientales que puede generar su disposición final y reducir el consumo de recursos no renovables.


Debe estar conectado para enviar un comentario.